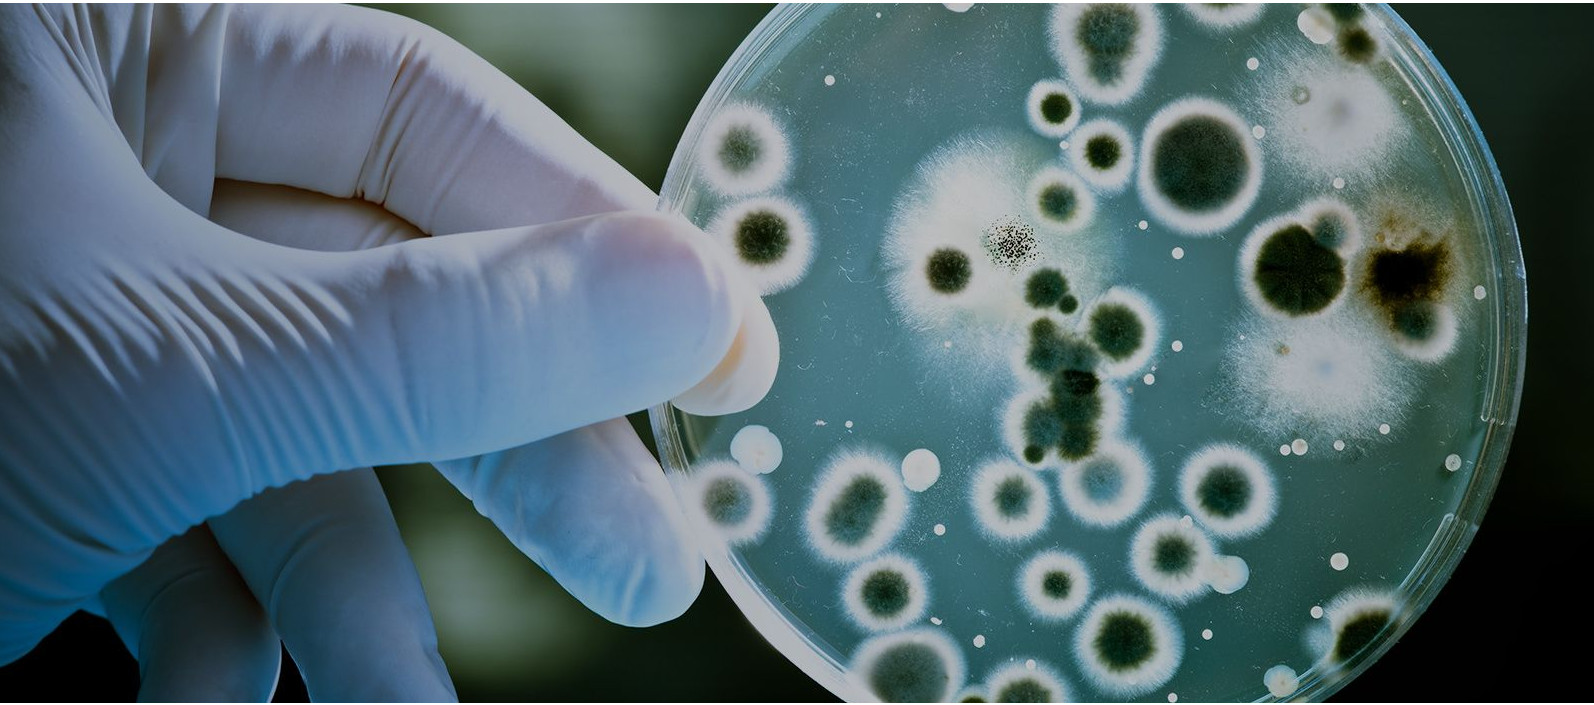
petri dish

Transforming how life sciences companies manage their most sensitive and vital information
In today’s fast-paced digital landscape, seamlessly migrating to Veeva Vault addresses the challenges of growing data volumes and complexity, evolving regulatory requirements and the need for operational efficiency.
Veeva Vault, the cloud-based platform designed for life sciences, provides a suite of applications for managing regulated content and data throughout the product lifecycle.
Transitioning precious customer data and content to Veeva Vault requires a team with the expertise to manage every intricacy of the migration. Our team brings a keen understanding of source systems and Veeva Vault, along with meticulous approach that ensures all data is accurately mapped, transferred and fully functional in its new target. Partner with Cognizant to help you navigate the challenges you will face during data migration to Veeva Vault.